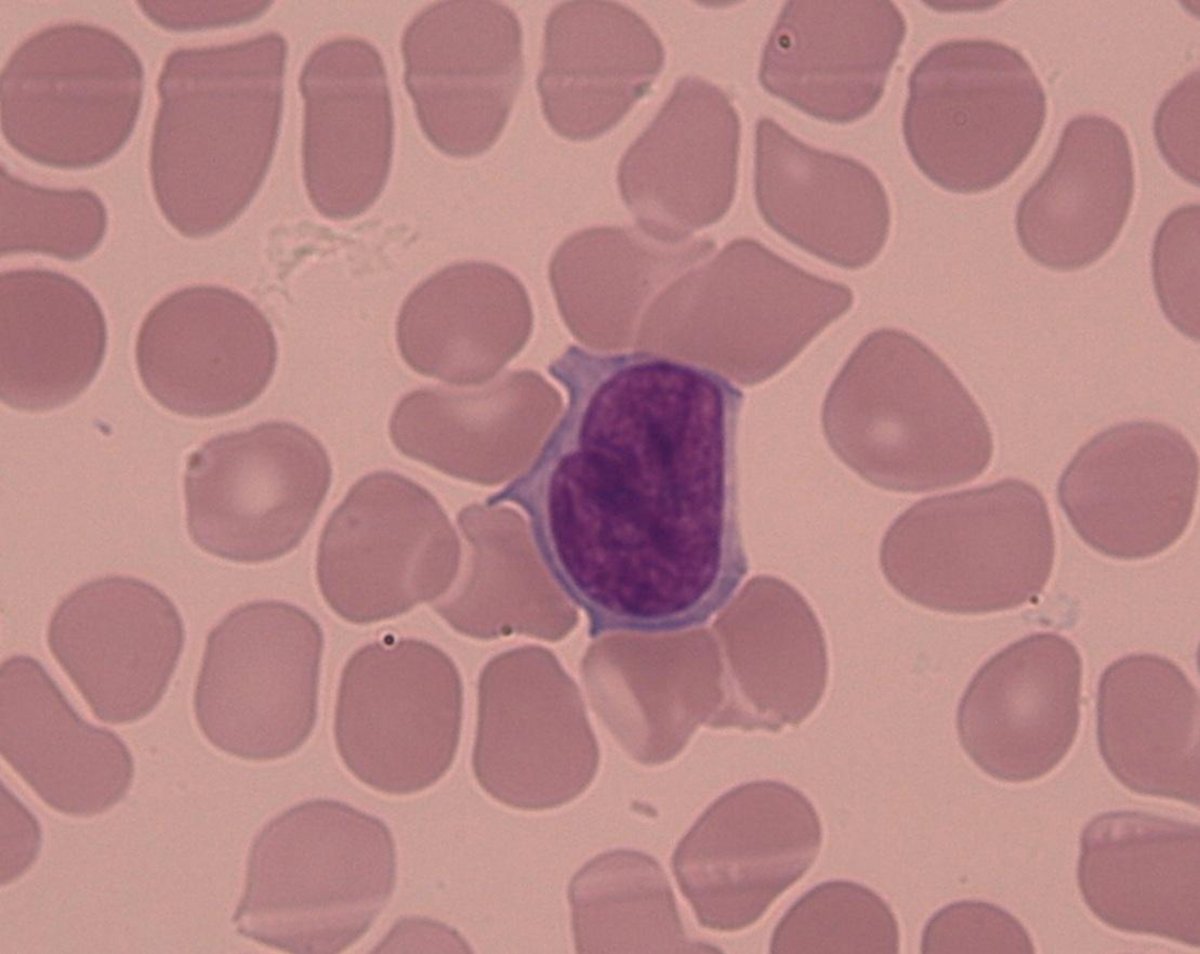
Sezary_cell

Medium size cell, irregular nucleus, typically cerebriform, with visible chromatin deep and narrow nuclear identations /grooves (chromatin aspect like fingernail scratch); elevated N / C ratio and slightly extended basophilic cytoplasm.
Epidermotropic T-cell Lymphoma (Sezary Syndrome).